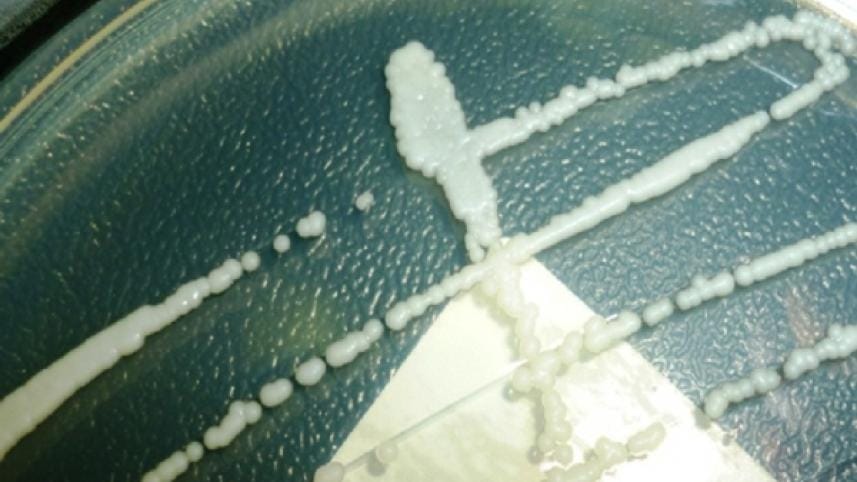
yeast infection.jpg

Yeast infection fails first US uterus transplant
The first uterus transplant in the US failed because of yeast infection, Cleveland Clinic, a multispecialty academic hospital located in Cleveland, Ohio, revealed on Friday.
Just two weeks after the procedure, which was on March 8, the failure of the operation was confirmed. But it was only now that a definitive reason has been confirmed, Tech Times reports today.
The 26-year-old patient, Lindsey McFarland was looking forward to having the surgery for it is her dream to become pregnant and have a child. That dream was fulfilled temporarily, but it only took an infection to cut it down short.
The world has been following the story of the first uterus transplant in the United States. Many were delighted that it finally pushed through. So, when the news of the failure broke, many were intrigued as to why it didn't work. The story only grew hotter when no absolute reason was determined by the hospital and its medical/surgical staff, reports the tech-based news portal.
Hospital Statement Released
Finally, Cleveland clinic released a one-paragraph statement regarding the transplant failure.
"Preliminary results suggest that the complication was due to an infection caused by an organism that is commonly found in a woman's reproductive system. The infection appears to have compromised the blood supply to the uterus, causing the need for its removal," the stament reads. "The health of our patient is and has always been our primary concern."
Cleveland clinic adds that review of all information is currently in place and that the team is tweaking protocols to prevent this situation from happening again.
Yeast Infection
The infection was caused by a fungus called Candida albicans. This organism commonly harbors in the vagina and co-exists with other bacteria and organisms. However, diseases or medications may disrupt the balance between these organisms, leading to an abnormally excessive growth of yeasts.
The yeast for the case could have come from either the donor or the recipient. Such possibility has prompted doctors to develop protocols of cleaning the organs to be transplanted in future operations.
Aside from the common effects of infection, McFarland was particularly more at risk of other complications because she was taking anti-rejection drugs. Such medicines do not only prevent rejection, they also hinder the immune system from battling infections. If the yeast infection reached the bloodstream, the situation could become worse and lead to death as it would be harder to manage.
History of Present Condition
McFarland underwent the nine-hour surgery on Feb. 24 and recovered well. However, on March 7, she bled tremendously, causing doctors to rush and make assessments.
The doctors found that the patient had an infection, which was not yet exactly known at time. What they were certain about was that the pathogen was damaging the blood vessels that provide blood to the uterus.
McFarland has since underwent two more operations. One for removing the uterus and another to treat more bleeding.
Now that the doctors are sure about the causative agent that caused the infection, they have prescribed the patient with antifungal medications. The patient has also stopped taking anti-rejection drugs, boosting her immunity to recover and fight the infection more efficiently.



 For all latest news, follow The Daily Star's Google News channel.
For all latest news, follow The Daily Star's Google News channel.
Comments